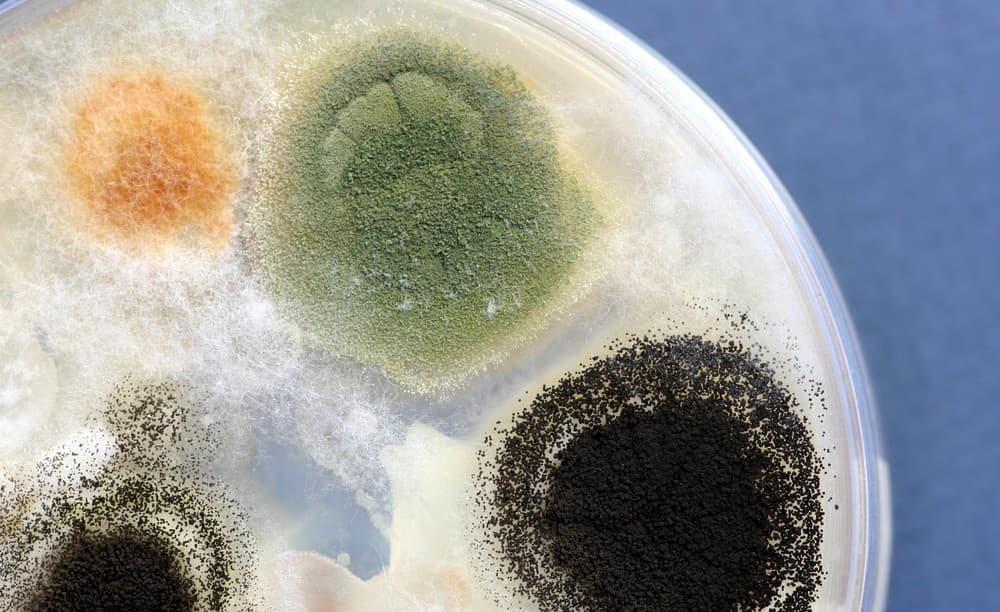

Los fungi, comúnmente referidos como « hongos», refieren a organismos eucariotas unicelulares como levaduras, mohos y setas. Estos organismos se clasifican en el reino Fungi, separado de las plantas, los animales y los protistas.
En Estados Unidos apareció un hongo letal que podría ser una gran amenaza para la humanidad
Esta clasificación se debe a que los hongos tienen características biológicas diferentes, como una pared celular compuesta por quitina en vez de celulosa.
- Quizá también quieras leer: «La ciencia descubre la verdadera causa del acné y mejores formas de tratarlo»
La distribución de los hongos

Lo hongos se pueden encontrar en distintos hábitats y se clasifican en cuatros grupos: parásitos, saprofitos, liquenizados y micorrizógenos. Además, se dividen en dos formas principales: los hongos filmentosos y los hongos levaduriformes.
En la naturaleza, tienen funciones ecológicas muy importantes ya que son los principales descomponedores de la materia muerta de plantas y animales. A su vez, en la industria, las levaduras son utilizadas en la fermentación de pan y cerveza, y algunas setas son consumidas.
Sin embargo, los hongos parásitos pueden producir una cantidad de enfermedades tanto en animales como en el humano. Recientemente, el Centro de Control y Prevención de Enfermedades de Estados Unidos reportó que hay varias muertes debido a un hongo que es resistente a todos los tratamientos antihongos existentes.
Candida auris, una nueva amenaza

El hongo se denomina Candida auris, ya que pertenece al género de hongos unicelulares o levaduras, Candida.
Este hongo provoca una infección a nivel de las lastimaduras y la sangre en las personas que se encuentran hospitalizadas y enfermas. Por lo tanto se comporta como las bacterias que ocasionan infecciones asociadas al sistema de salud, como MRSA, Klebsiella y Acinetobacter.
Tal como sucede con estas bacterias, C. auris ocasiona infecciones graves que saturan el sistema inmune. Este es un comportamiento ya observado en bacterias, empero, los hongos nunca antes habían tenido este comportamiento.
La rápida expansión de C. auris

En el 2009, un paciente en Japón se enfermó en el hospital con C. auris y nunca respondió al tratamiento antifúngico. Este año, el mismo hongo se reportó en Corea del Sur, India, Kuwait, y Sudáfrica. En octubre, un brote del hongo enfermó a 50 pacientes en Londres. Ahora, en Estados Unidos por segunda vez hay una alerta por este microorganismo, que parecería ser el mismo que también circula en Asia del Sur y América del Sur.
Lo más inquietante es que actualmente no hay suficientes defensas contra los hongos. Esto se debe a que las farmaceúticas no consideran que haya un mercado para las drogas antifúngicas. De hecho, actualmente hay solo 3 tipos de drogas antiúngicas posibles ante las cuales C. auris ha demostrado total resistencia.
Candida auris no está actuando como un hongo típico y esto es lo que mas asusta a la comunidad científica. Sobre todo porque está infectando rápidamente a personas que ya se encuentran con el sistema inmune comprometido y esta es la clave para una gran expansión.
También te recomendamos leer: